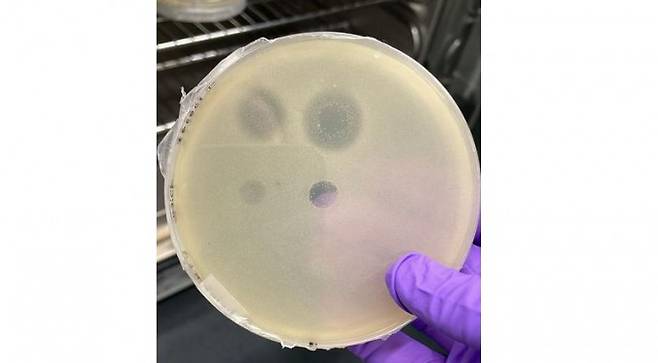
연구팀이 페트리 접시에 배양한 세균 ‘할랄칼리박테리움 할로두란스’의 모습. 이 세균은 고세균 ‘할로그라눔 살라리움’이 분비하는 단백질에 의해 사멸될 수 있다. Aida Sanchez-Ricol 제공.

슈퍼박테리아 대항마 고세균은 '항생제 보고'
전체 맥락을 이해하기 위해서는 본문 보기를 권장합니다.
항생제가 듣지 않는 내성균(슈퍼박테리아)은 전세계적으로 공중보건 위협이 되고 있다.
고세균이 내성균을 사멸시킬 수 있는 새로운 항생제가 될 수 있을 가능성이 제시됐다.
토비아스 웨네크 영국 옥스퍼드대 생화학과 교수 연구팀은 고세균에서 합성되는 단백질이 항생제가 될 가능성을 확인하고 연구결과를 국제학술지 'PLOS 바이올로지'에 14일 발표했다.
이 글자크기로 변경됩니다.
(예시) 가장 빠른 뉴스가 있고 다양한 정보, 쌍방향 소통이 숨쉬는 다음뉴스를 만나보세요. 다음뉴스는 국내외 주요이슈와 실시간 속보, 문화생활 및 다양한 분야의 뉴스를 입체적으로 전달하고 있습니다.
항생제가 듣지 않는 내성균(슈퍼박테리아)은 전세계적으로 공중보건 위협이 되고 있다. 고세균이 내성균을 사멸시킬 수 있는 새로운 항생제가 될 수 있을 가능성이 제시됐다.
토비아스 웨네크 영국 옥스퍼드대 생화학과 교수 연구팀은 고세균에서 합성되는 단백질이 항생제가 될 가능성을 확인하고 연구결과를 국제학술지 'PLOS 바이올로지'에 14일 발표했다.
고세균은 세균, 진핵생물과 함께 3가지 생물역을 이루는 생물 분류군이다. 세균과 마찬가지로 원핵생물이지만 다른 계통으로 분류된다. 사람이 포함된 진핵생물과 분자생물학적으로 유사성을 가진다.
고세균은 한정된 공간 및 자원을 두고 세균과 끊임없이 경쟁한다. 약 2만종에 달하는 고세균은 세균과의 경쟁에서 살아남기 위해 세균에 대항할 수 있는 다양한 노하우를 갖고 있다.
연구팀은 고세균이 인간이 아직 개척하지 않은 ‘항생제 보고’일 것으로 가정하고 고세균의 무기고를 살피는 연구를 진행했다. 고세균 3700여종의 유전체를 조사해 세균을 제거하는 기능을 하는 단백질을 암호화할 수 있는 유전자를 분석한 것이다.
연구팀은 세균의 세포벽을 이루는 필수 구성 성분인 ‘펩티도글리칸’ 분자를 절단할 수 있는 단백질을 암호화하는 고세균 유전자 찾기에 초점을 뒀다.
조사 결과 3700여종의 고세균 중 약 5%가 펩티도글리칸 분자를 절단할 수 있는 단백질을 생산할 수 있다는 점이 확인됐다. 연구팀이 실험실에서 고세균이 생산한 단백질을 세균에 적용하자 세균이 성공적으로 사멸됐다.
고세균이 생산하는 펩티도글리칸 절단 단백질은 대체로 고세균 세포의 외부에 위치했다. 일부 고세균은 생존을 위해 경쟁하는 세균에 펩티도글리칸 절단 단백질을 직접 전달할 수 있는 시스템을 갖추고 있는 것으로 확인됐다.
연구팀은 “고세균은 세균 및 진핵생물과 다른 고유한 생명 영역”이라며 “고세균이 세균과 어떻게 상호 작용하는지 많이 알려진 부분은 없다”고 말했다. 이어 “이번 연구는 고세균에 대한 이해를 높였을 뿐 아니라 고세균이 세균에 미치는 영향을 살펴 고세균이 새로운 항생제 개발의 중요한 단서가 될 수 있음을 시사한다”고 덧붙였다.
<참고 자료>
doi.org/10.1371/journal.pbio.3003235
[문세영 기자 moon09@donga.com]
Copyright © 동아사이언스. 무단전재 및 재배포 금지.